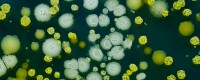

footerdirkswelcome | 
graddeptafricanamericanstudies | 
graddeptagriculturalandresourceeconomics |

graddeptancienthistorymediterraneanarchaelogy | 
graddeptanthropology | 
graddeptappliedsciencetechnology |

graddeptarchitecture | 
graddeptarchitecture-banner | 
graddeptarthistoryof |

graddeptartpracticeof | 
graddeptasianstudies | 
graddeptastronomy |

graddeptbioengineering | 
graddeptbiophysics | 
graddeptbiostatistics |

graddeptbuddhiststudies | 
graddeptchemicalandbiomoleularengineering | 
graddeptchemistry |

graddeptchemistry-banner | 
graddeptcityandregionalplanning | 
graddeptcivilenvironmentalengineering |

graddeptcivilenvironmentalengineering-banner | 
graddeptclassics | 
graddeptcommunicationcomputationstatistics |

graddeptcomparativebiochemistry | 
graddeptcomparativeliterature | 
graddeptcomparativeliterature-banner |

graddeptcomputationalbiology | 
graddeptcomputationalscienceengineering | 
graddeptcriticaltheory |

graddeptdemography | 
graddeptdevelopmentengineering | 
graddeptdevelopmentpractice |

graddeptdutchstudies | 
graddeptearthandplanetaryscience | 
graddepteastasianlanguagescultures |

graddepteconomics | 
graddeptelectricalengineeringcomputersciences | 
graddeptendocrinology |

graddeptenergyresources | 
graddeptenergysciencetechnology | 
graddeptenglish |

graddeptenvironmentalhealthsciences | 
graddeptenvironmentalsciencepolicymanagement | 
graddeptepidemiology |

graddeptethnicstudies | 
graddeptfilmandmedia | 
graddeptfolklore |

graddeptfrench | 
graddeptfrench-banner | 
graddeptgeography |

graddeptgerman | 
graddeptglobalmetropolitanstudies | 
graddeptgoldmanschoolofpublicpolicy |

graddeptgradstudentprofessionaldevelopment | 
graddeptgraduateschoolofeducation | 
graddeptgraduateschoolofjournalism |

graddepthaasschoolofbusiness | 
graddepthealthandmedicalsciences | 
graddepthealthserviceandpolicyanalysis |

graddepthistory | 
graddeptindustrialengineeringoperationsresearch | 
graddeptinfectiousdiseasesimmunity |

graddeptintegrativebiology | 
graddeptinternationalareastudies | 
graddeptitalianstudies |

graddeptjewishstudies | 
graddeptjurisprudencesocialpolicy | 
graddeptlandscapearchitectureenvironmentalplanning |

graddeptlatinamericanstudies | 
graddeptlinguistics | 
graddeptlinguistics-banner |

graddeptlogicthemethodologyofscience | 
graddeptmaterialsscienceengineering | 
graddeptmaterialsscienceengineering-banner |

graddeptmathematics | 
graddeptmathematics-banner | 
graddeptmechanicalengineering |

graddeptmechanicalengineering-banner | 
graddeptmedicalanthropology | 
graddeptmedievalstudies |

graddeptmetabolicbiology | 
graddeptmicrobiology | 
graddeptmolecularcellbiology |

graddeptmoleculartoxicology | 
graddeptmusic | 
graddeptnanoscalescienceengineering |

graddeptnanoscalescienceengineering-banner | 
graddeptneareasternstudies | 
graddeptneareasternstudies-banner |

graddeptneuroscience | 
graddeptnewmedia | 
graddeptnuclearengineering |

graddeptperformancestudies | 
graddeptperformancestudies-banner | 
graddeptperformancstudies |

graddeptperformancstudies-banner | 
graddeptphilosophy | 
graddeptphysics |

graddeptplantandmicrobial | 
gradprogramaarthistoryof | 
gradprogramafricanamericanstudies |

gradprogramafricanamericanstudies-banner | 
gradprogramagriculturalresourceeconomics | 
gradprogramagriculturalresourceeconomics-banner |

gradprogramancienthistoryandancientneareasternandmediterraneanarchaeology | 
gradprogramanthropology | 
gradprogramappliedmathematics |

gradprogramappliedsciencetechnology | 
gradprogramappliedsciencetechnology-banner | 
gradprogramarchitecture |

gradprogramartparcticeof | 
gradprogramartparcticeof-banner | 
gradprogramasianstudies |

gradprogramasianstudies-banner | 
gradprogramastrophysics | 
gradprogramastrophysics-banner |

gradprogrambioengineering | 
gradprogrambioengineering-banner | 
gradprogrambiophysics |

gradprogrambiophysics-banner | 
gradprogrambiostatistics | 
gradprogrambuddhiststudies |

gradprogrambuddhiststudies-banner | 
gradprogrambusinessadministrationeveningweekendmbaprogram | 
gradprogrambusinessadministrationeveningweekendmbaprogram-banner |

gradprogrambusinessadministrationfulltimembaprogram | 
gradprogrambusinessadministrationfulltimembaprogram-banner | 
gradprogrambusinessadministrationmaster'sinfinancialengineeringprogram |

gradprogrambusinessadministrationmbaforexecutives | 
gradprogrambusinessadministrationphd | 
gradprogramchemicalandbiomolecularengineering |

gradprogramchemicalandbiomolecularengineering-banner | 
gradprogramchemistry | 
gradprogramchineselanguage |

gradprogramcityregionalplanning | 
gradprogramcivilandenvironmentalengineering | 
gradprogramcivilandenvironmentalengineering-banner |

gradprogramclassicalarchaeology | 
gradprogramclassicalarchaeology-banner | 
gradprogramclassics |

gradprogramclassics-banner | 
gradprogramcommunicationcomputationstatistics | 
gradprogramcomparativebiochemistry |

gradprogramcomparativebiochemistry-banner | 
gradprogramcomparativeliterature | 
gradprogramcomparativeliterature-banner |

gradprogramcomputationalbiology | 
gradprogramcomputationalscienceengineering | 
gradprogramcomputerscience |

gradprogramcriticaltheory | 
gradprogramdemography | 
gradprogramdevelopmentengineering |

gradprogramdevelopmentpractice | 
gradprogramdutchstudies | 
gradprogramearthplanetaryscience |

gradprogrameconomics | 
gradprogrameducation | 
gradprogramelectricalengineeringcomputersciences |

gradprogramelectricalengineeringcomputersciences-banner | 
gradprogramendocrinology | 
gradprogramenergyresources |

gradprogramenergysciencetechnology | 
gradprogramenglish | 
gradprogramenvironmentalhealthsciences |

gradprogramenvironmentalsciencepolicymanagement | 
gradprogramepidemiology | 
gradprogramethnicstudies |

gradprogramfilmmedia | 
gradprogramfinancialengineering | 
gradprogramfolklore |

gradprogramforestry | 
gradprogramfrench | 
gradprogramgeography |

gradprogramgerman | 
gradprogramglobalmetropolitanstudies | -thumb.jpg)
gradprogramhealthmedicalsciencesmedicalprogram(jointprogramwithucsf) |

gradprogramhealthmedicalsciencesmedicalprogramjointprogramwithucsf | 
gradprogramhealthservicespolicyanalysis | 
gradprogramhispaniclanguagesliteratures |

gradprogramhistory | -thumb.jpg)
gradprogramhistoryofart(arthistoryof) | 
gradprogramindustrialengineeringoperationsresearch |

gradprograminfectiousdiseasesandimmunity | 
gradprograminfectiousdiseasesimmunity | 
gradprograminformationanddatascience |

gradprograminformationanddatascience-banner | 
gradprograminformationmanagementsystems | 
gradprograminformationmanagementandsystemsmims |

gradprogramintegratedcircuits | 
gradprogramintegrativebiology | 
gradprogramitalianstudies |

gradprogramjapaneselanguage | 
gradprogramjewishstudies | 
gradprogramjournalism |

gradprogramjurisprudencesocialpolicy | 
gradprogramlandscapearchitecture | 
gradprogramlandscapearchitectureenvironmentalplanning |

gradprogramlatinamericanstudies | 
gradprogramlawjd | 
gradprogramlinguistics |

gradprogramlogicthemethodologyofscience | 
ugdeptafricanamericanstudies | 
ugdeptagriculturalandresourceeconomics |

ugdeptarthistory | 
ugdeptasianstudies | 
ugdeptastronomy |

ugdeptchemicalandbiomolecularengineering | 
ugdeptcityandregionalplanning | 
ugdeptcivilandenvironmentalengineering |

ugdeptclassics | 
ugdeptcognitivescience | 
ugdeptcollegewriting |

ugdeptcomparativeliterature | 
ugdeptcomputationalandgenomicbiology | 
ugdeptdemography |

ugdeptdevelopmentstudies | 
ugdeptearthandplanetaryscience | 
ugdepteastasianlanguagesandcultures |

ugdepteconomics | 
ugdepteducation | 
ugdeptelectricalengineering |

ugdeptelectricalengineeringandcomputersciences | 
ugdeptenergyandresources | 
ugdeptenglish |

ugdeptenvironmentalsciencepolicyandmanagement | 
ugdeptethnicstudies | 
ugdeptfilmandmedia |

ugdeptfrench | 
ugdeptgenderandwomen'sstudies | 
ugdeptgeography |

ugdeptgerman | 
ugdeptglobalpovertyandpractice | 
ugdepthistory |

ugdepthistoryofart | 
ugdeptindustrialengineeringandoperationsresearch | 
ugdeptintegrativebiology |

ugdeptinterdisciplinarystudies | 
ugdeptitalianstudies | 
ugdeptjewishstudiescenterfor |

ugdeptlandscapearchitecture | 
ugdeptlatinamericanstudies | 
ugdeptlegalstudies |

ugdeptlinguistics | 
ugdeptmaterialsscienceandengineering | 
ugdeptmathematics |

ugdeptmechanicalengineering | 
ugdeptmilitaryaffairs | 
ugdeptmolecularandcellbiology |

ugdeptmusic | 
ugdeptneareasternstudies | 
ugdeptnuclearengineering |

ugdeptnutritionalsciencesandtoxicology | 
ugdeptphilosophy | 
ugdeptphysicaleducation |

ugdeptphysics | 
ugdeptplantandmicrobialbiology | 
ugdeptpoliticaleconomy |

ugdeptpoliticalscience | 
ugdeptpracticeofart | 
ugdeptprograminmedievalstudies |

ugdeptpsychology | 
ugdeptpublichealth | 
ugdeptpublicpolicy |

ugdeptreligiousstudies | 
ugdeptrhetoric | 
ugdeptscandinavian |

ugdeptslaviclanguagesandliteratures | 
ugdeptsocialwelfare | 
ugdeptsociology |

ugdeptspanishandportuguese | 
ugdeptstatistics | 
ugdepttheaterdanceandperformancestudies |

ugdeptundergraduateandinterdisciplinarystudies | 
dsc9177 | 
img7760 |

ugprogramafricanamericanstudies | 
ugprogramafricanamericanstudies-banner | 
ugprogramamericanstudies |

ugprogramancientegyptianandneareasternartandarchaeology | 
ugprogramancientegyptianandneareasternartandarchaeology-banner | 
ugprogramancientegyptianandneareasterncivilizations |

ugprogramancientegyptianandneareasterncivilizations-banner | 
ugprogramanthroplogy | 
ugprogramappliedlanguagestudies |

ugprogramappliedlanguagestudies-banner | 
ugprogramappliedmathematics | 
ugprogramappliedmathematics-banner |

ugprogramarabic | 
ugprogramarabic-banner | 
ugprogramarchitecture |

ugprogramarthistoryof | 
ugprogramarthistoryof-banner | 
ugprogramartpractice |

ugprogramartpracticeof | 
ugprogramasianamericanandasiandiasporastudies | 
ugprogramasianamericanandasiandiasporastudies-banner |

ugprogramasianstudieschina | 
ugprogramasianstudieschina-banner | 
ugprogramasianstudiesjapan |

ugprogramasianstudiesjapan-banner | 
ugprogramastrophysics | 
ugprogramasianstudiesmultiarea |

ugprogramastrophysics-banner | 
ugprogramatmosphericscience | 
ugprogramatmosphericscience-banner |

ugprogrambioengineering | 
ugprogrambioengineeringmaterialsscienceandengineeringjointmajor | 
ugprogrambioengineeringmaterialsscienceandengineeringjointmajor-banner |

ugprogrambuddhism | 
ugprogrambuddhism-banner | 
ugprogrambusinessadmin |

ugprogramcelticstudies | 
ugprogramchemicalbiology | 
ugprogramchemicalbiology-banner |

ugprogramchemicalengineering | 
ugprogramchemicalengineering-banner | 
ugprogramchemicalengineeringmaterialsscienceandengineeringjointmajor |

ugprogramchemicalengineeringmaterialsscienceandengineeringjointmajor-banner | 
ugprogramchemicalengineeringnuclear | 
ugprogramchemicalengineeringnuclearengineeringjointmajor |

ugprogramchemicalengineeringnuclearengineeringjointmajor-banner | 
ugprogramchemistry | 
ugprogramchemistry-banner |

ugprogramchicanolatinostudies | 
ugprogramchicanolatinostudies-banner | 
ugprogramchineselanguage |

ugprogramchineselanguage-banner | 
ugprogramchinesestudies | 
ugprogramchinesestudies-banner |

ugprogramcityandregionalplanning | 
ugprogramcityandregionalplanning-banner | 
ugprogramcivilengineering |

ugprogramclassicalcivilizations | 
ugprogramclassicalcivilizations-banner | 
ugprogramclassicallanguages |

ugprogramclassicallanguages-banner | 
ugprogramcognitivescience | 
ugprogramcognitivescience-banner |

ugprogramcomparativeliterature | 
ugprogramcomparativeliterature-banner | 
ugprogramcomputerscience |

ugprogramcomputerscience-banner | 
ugprogramconservationandresourcestudies | 
ugprogramconservationandresourcestudies-banner |

ugprogramcreativewriting | 
ugprogramcreativewriting-banner | 
ugprogramczechpolishorbosniancroatianserbianlanguageandliterature |

ugprogramczechpolishorbosniancroatianserbianlanguageandliterature-banner | 
ugprogramdanceandperformancestudies | 
ugprogramdanceandperformancestudies-banner |

ugprogramdemography | 
ugprogramdevelopmentstudies | 
ugprogramdevelopmentstudies-banner |

ugprogramdisabilitystudies | 
ugprogramdisabilitystudies-banner | 
ugprogramdutchstudies |

ugprogramdutchstudies-banner | 
ugprogramdutchstudies-banner-1 | 
ugprogrameastasianreligionthoughtandculture |

ugprogrameastasianreligionthoughtandculture-banner | 
ugprogrameconomics | 
ugprogrameconomics-banner |

ugprogrameducation | 
ugprogramelectricalengineeringandcomputersciences | 
ugprogramelectricalengineeringandcomputersciences-banner |

ugprogramelectricalengineeringandcomputersciencesmaterialsscienceandengineeringjointmajor | 
ugprogramelectricalengineeringandcomputersciencesmaterialsscienceandengineeringjointmajor-banner | 
ugprogramelectricalengineeringandcomputersciencesnuclearengineeringjointmajor |

ugprogramelectricalengineeringandcomputersciencesnuclearengineeringjointmajor-banner | 
ugprogramenergyandresources | 
ugprogramenergyandresources-banner |

ugprogramenergyengineering | 
ugprogramenergyengineering-banner | 
ugprogramengineeringmathandstatistics |

ugprogramengineeringmathandstatistics-banner | 
ugprogramengineeringphysics | 
ugprogramengineeringphysics-banner |

ugprogramenglish | 
ugprogramenglish-banner | 
ugprogramenviornmentaldesignandurbanismindevelopingcountries |

ugprogramenviornmentaldesignandurbanismindevelopingcountries-banner | 
ugprogramenvironmentalearthscience | 
ugprogramenvironmentalearthscience-banner |

ugprogramenvironmentaleconomicsandpolicy | 
ugprogramenvironmentaleconomicsandpolicy-banner | 
ugprogramenvironmentalengineering |

ugprogramenvironmentalengineering-banner | 
ugprogramenvironmentalengineeringscience | 
ugprogramenvironmentalengineeringscience-banner |

ugprogramenvironmentalsciences | 
ugprogramethnicstudies | 
ugprogramethnicstudies-banner |

ugprogramfilm | 
ugprogramfoodsystems | 
ugprogramforestryandnaturalresources |

ugprogramforestryandnaturalresources-banner | 
ugprogramfrench | 
ugprogramfrenchcivilization |

ugprogramfrenchcivilization-banner | 
ugprogramfrenchlanguagestudies | 
ugprogramfrenchlanguagestudies-banner |

ugprogramfrenchliterature | 
ugprogramfrenchliterature-banner | 
ugprogramgenderandwomen'sstudies |

ugprogramgenderandwomen'sstudies-banner | 
ugprogramgeneticsandplantbiology | 
ugprogramgeneticsandplantbiology-banner |

ugprogramgeoengineering | 
ugprogramgeoengineering-banner | 
ugprogramgeography |

ugprogramgeography-banner | 
ugprogramgeology | 
ugprogramgeology-banner |

ugprogramgeophysics | 
ugprogramgeophysics-banner | 
ugprogramgeospatialinformationscienceandtechnology |

ugprogramgeospatialinformationscienceandtechnology-banner | 
ugdeptamericanstudies-banner | 
ugprogramgerman |

ugprogramgerman-banner | 
ugprogramglobalpovertyandpractice | 
ugdeptanthropology-banner |

ugprogramglobalpovertyandpractice-banner | 
ugprogramgreek | 
ugprogramgreek-banner |

ugprogramhebrew | 
ugprogramhebrew-banner | 
ugprogramhispaniclanguagesandbilingualissues |

ugprogramhispaniclanguagesandbilingualissues-banner | 
ugprogramhistory | 
ugprogramhistory-banner |

ugprogramhistoryofthebuiltenvironment | 
ugprogramhistoryofthebuiltenvironment-banner | 
ugprogramhumanrightsinterdisciplinary |

ugprogramhumanrightsinterdisciplinary-banner | 
ugprogramhumanrightsinterdisciplinary-banner-1 | 
ugprogramiberianlanguageandliterature |

ugprogramiberianlanguageandliterature-banner | 
ugprogramindustrialengineeringandoperationsresearch | 
ugprogramindustrialengineeringandoperationsresearch-banner |

ugprogramindustrialengineeringandoperationsresearch-banner-1 | 
ugprogramintegrativebiology | 
ugprogramintegrativebiology-banner |

ugprograminterdisciplinarystudies | 
ugprograminterdisciplinarystudies-banner | 
ugprogramitalianstudies |

ugprogramjapaneselanguage | 
ugprogramjapaneselanguage-banner | 
ugprogramjapanesestudies |

ugprogramjapanesestudies-banner | 
ugprogramjewishstudies | 
ugprogramjewishstudies-banner |

ugprogramjournalism | 
ugprogramkoreanlanguage | 
ugprogramkoreanlanguage-banner |

ugprogramkoreanstudies | 
ugprogramkoreanstudies-banner | 
ugprogramlandscapearchitecture |

ugprogramlandscapearchitecture-banner | 
ugprogramlatin | 
ugprogramlatin-banner |

ugprogramlatinamericanliteratures | 
ugprogramlatinamericanliteratures-banner | 
ugprogramlatinamericanstudies |

ugprogramlatinamericanstudies-banner | 
ugprogramlegalstudies | 
ugprogramlegalstudies-banner |

ugprogramlesbiangaybisexualandtransgenderstudies | 
ugprogramlinguistics | 
ugprogramlinguistics-banner |

ugprogramlusobrazilianlanguageandliterature | 
ugprogramlusobrazilianlanguageandliterature-banner | 
ugprogrammarinescience |

ugprogrammarinescience-banner | 
ugprogrammaterialsscienceandengineering | 
ugprogrammaterialsscienceandengineering-banner |

ugprogrammaterialsscienceandengineeringmechanicalengineeringjointmajor | 
ugprogrammaterialsscienceandengineeringmechanicalengineeringjointmajor-banner | 
ugprogrammaterialsscienceandengineeringnuclearengineeringjointmajor |

ugprogrammaterialsscienceandengineeringnuclearengineeringjointmajor-banner | 
ugprogrammathematics | 
ugprogrammathematics2 |

ugprogrammathematics-banner | 
ugprogrammechanicalengineering | 
ugprogrammechanicalengineering-banner |

ugprogrammechanicalengineeringnuclearengineering | 
ugprogrammechanicalengineeringnuclearengineering-banner | 
ugprogrammediastudies |

ugprogrammedievalstudies | 
ugprogrammedievalstudies-banner | 
ugprogrammicrobialbiology |

ugprogrammicrobialbiology-banner | 
ugprogrammiddleeasternstudies | 
ugprogrammiddleeasternstudies-banner |

ugprogrammolecularandcellbiologybiochemistryandmolecularbiology | 
ugprogrammolecularandcellbiologybiochemandmolebio | 
ugprogrammolecularandcellbiologycellanddevelopmentalbiology |

ugprogrammolecularandcellbiologycellanddevelopmentalbiology-banner | 
ugprogrammolecularandcellbiologygeneticsgenomicsanddevelopment | 
ugprogrammolecularandcellbiologygeneticsgenomicsanddevelopment-banner |

ugprogrammolecularandcellbiologyimmunologyandpathogenesis | 
ugprogrammolecularandcellbiologyimmunologyandpathogenesis-banner | 
ugprogrammolecularandcellbiologyneurobiology |

ugprogrammolecularandcellbiologyneurobiology-banner | 
ugprogrammolecularenvironmentalbiology | 
ugprogrammolecularenvironmentalbiology-banner |

ugprogrammoleculartoxicology | 
ugprogrammusic | 
ugprogrammusic-banner |

ugprogramnativeamericanstudies | 
ugprogramnativeamericanstudies-banner | 
ugprogramneareasterncivilizations |

ugprogramneareasterncivilizations-banner | 
ugprogramneareasternlanguagesandliteratures | 
ugprogramneareasternlanguagesandliteratures-banner |

ugprogramnuclearengineering | 
ugprogramnuclearengineering-banner | 
ugprogramnutritionalscience |

ugprogramnutritionalscience-banner | 
ugprogramoperationsresearchandmanagementscience | 
ugprogramoperationsresearchandmanagementscience-banner |

ugprogrampeaceandconflictstudies | 
ugprogrampeaceandconflictstudies-banner | 
ugprogrampersian |

ugprogrampersian-banner | 
ugprogramphilosophy | 
ugprogramphysics |

ugprogramphysics-banner | 
ugprogrampoliticaleconomy | 
ugprogrampoliticaleconomy-banner |

ugprogrampoliticalscience | 
ugprogrampoliticalscience-banner | 
ugprogrampsychology |

ugprogrampublichealth | 
ugprogrampublichealth-banner | 
ugprogrampublicpolicy |

ugprogrampublicpolicy | 
ugprogramreligiousstudies | 
ugprogramrhetoric |

ugprogramrussianlanguage | 
ugprogramrussianlanguageliteratureandculture | 
ugprogramrussianlanguageliteratureandculture-banner |

ugdeptpeaceandconflictstudies | 
ugdeptmedievalstudies | 
ugdeptmiddleeasternstudies |

ugdeptengineeringscience | 
ugdeptmediastudies | 
ugdeptartpracticeof |

ugdeptbiologygeneral | 
graddeptpoliticalscience | 
graddeptpsychology |

ugprogramrussianliterature | 
ugprogramrussianliterature-banner | 
ugprogramscandinavian |

ugprogramscandinavian-banner | 
graddeptearthandplanetaryscience-banner | 
ugprogramscienceandmatheducation |

ugprogramscienceandmatheducation-banner | 
ugprogramslaviclanguagesliteratures | 
ugprogramsocialandculturalfactorsinenviornmentaldesign |

ugprogramsocialandculturalfactorsinenviornmentaldesign-banner | 
ugprogramsocialwelfare | 
ugprogramsocietyandenvironment |

ugprogramsocietyandenvironment-banner | 
ugprogramsociology | 
ugprogramsociology-banner |

ugprogramsouthandsoutheastasianstudies | 
ugdeptamericanstudies | 
ugdeptfrench-banner |

ugdeptenglish-banner | 
ugdepteconomics-banner | 
ugdeptenergyandresources-banner |

graddeptrangemanagement | 
ugdeptfilmandmedia-banner | 
ugdeptbioengineering-banner |

ugdeptelectricalengineeringandcomputersciences-banner | 
ugdeptcivilandenvironmentalengineering-banner | 
ugdeptchemicalandbiomolecularengineering-banner |

ugdeptethnicstudies-banner | 
ugdepteastasianlanguagesandcultures-banner | 
ugdeptenvironmentalsciencepolicyandmanagement-banner |

ugdeptdevelopmentstudies-banner | 
ugdeptearthandplanetaryscience-banner | 
ugdeptcityandregionalplanning-banner |

ugdeptagriculturalandresourceeconomics-banner | 
ugdeptarchitecture-banner | 
ugdeptastronomy-banner |

ugdeptcognitivescience-banner | 
ugdeptafricanamericanstudies-banner | 
ugdeptasianstudies-banner |

ugdeptarthistory-banner | 
ugdeptclassics-banner | 
ugdeptcollegewriting-banner |

ugdeptdemography-banner | 
ugdeptcomparativeliterature-banner | 
ugdeptgenderandwomen'sstudies-banner |

ugdeptgerman-banner | 
ugdeptlinguistics-banner | 
gradprogrammaterialsscienceengineering |

ugdeptintegrativebiology-banner | 
ugdeptnuclearengineering-banner | 
ugdeptmaterialsscienceandengineering-banner |

ugdeptnutritionalsciencesandtoxicology-banner | 
ugdeptmathematics-banner | 
ugdeptphilosophy-banner |

ugdeptmechanicalengineering-banner | 
ugdeptjewishstudiescenterfor-banner | 
ugdeptphysics-banner |

ugdeptmolecularandcellbiology-banner | 
ugdeptplantandmicrobialbiology-banner | 
ugdeptgeography-banner |

ugdeptglobalpovertyandpractice-banner | 
ugdeptlandscapearchitecture-banner | 
ugdeptlatinamericanstudies-banner |

ugdeptindustrialengineeringandoperationsresearch-banner | 
ugdeptmilitaryaffairs-banner | 
ugdeptphysicaleducation-banner |

ugdeptmusic-banner | 
ugdeptlegalstudies-banner | 
ugdeptneareasternstudies-banner |

ugdeptpoliticaleconomy-banner | 
gradprogrammathematics | 
gradprogrammechanicalengineering |

gradprogrammedicalanthropologyjointprogramwithucsf | 
ugdeptpoliticalscience-banner | 
ugdeptundergraduateandinterdisciplinarystudies-banner |

ugdeptsociology-banner | -thumb.jpg)
gradprogrammedicalanthropology(jointprogramwithucsf) | 
ugdeptscandinavian-banner |

ugdeptbiologygeneral-banner | 
gradprogrammedievalstudies | 
gradprogrammetabolicbiology |

gradprogrammetabolicbiology-banner | 
gradprogrammicrobiology | 
gradprogrammolecularandcellbiology |

gradprogrammoleculartoxicology | 
gradprogrammusic | 
gradprogramnanoscalescienceengineering |

gradprogramneareasternstudies | 
gradprogramneuroscience | 
gradprogramnewmedia |
-thumb.jpg)
gradprogramnuclearengineering(masterofengineering) | -thumb.jpg)
gradprogramoptometry(residencyprogram) | 
gradprogramoptometry |

gradprogramperformancestudies | 
ugdeptintegrativebiologyjpg | 
ugprogramspanishlangaugeandliterature |

home | 
gradprogramphilosophy | 
gradprogramphysics |

gradprogramplantbiology | 
gradprogrampoliticalscience | 
gradprogrampsychology |

gradprogrampublichealth | 
gradprogrampublicpolicy | 
graddeptrenaissanceearlymodernstudies |

graddeptrhetoric | 
graddeptromancelanguagesandliteratures | 
ugprogramspanishlangaugeandliterature-banner |

ugprogramspanishlinguistics | 
gradprogramrangemanagement | 
ugprogramspanishlinguistics-banner |

ugdeptbuddhiststudies | 
genderwomenstudies | 
ugprogramstatistics |

ugdeptarchitecture | 
gradprogramrenaissanceearlymodernstudies | 
ugprogramstatistics-banner |

ugprogramstructuralengineering | 
gradprogramrhetoric | 
gradprogramromancelanguagesliteraturesfrench |

gradprogramromancelanguagesliteraturesitalian | 
gradprogramromancelanguagesliteraturesspansih | 
gradprogramscandinavianlanguagesliteratures |

gradprogramscienceandmathematicseducation | 
gradprogramsciencetechnologystudies | 
ugprogramstructuralengineering-banner |

ugprogramsustainabledesign | 
ugprogramsustainabledesign-banner | 
gradprogramslaviclanguagesliteratures |

gradprogramsocialwelfare | 
ugprogramsustainabledesign-banner-banner | 
ugprogramsustainableenvironmentaldesign |

gradprogramsociology | 
gradprogramsociologydemography | 
graddeptscandinavianlanguagesliteratures |

ugprogramsustainableenvironmentaldesign-banner | 
gradprogramsouthandsoutheastasianstudies | 
ugdeptsouthandsoutheastasianstudies |

graddeptschoolofinformation | 
graddeptschoolofoptometry | 
graddeptschoolofpublichealth |

graddeptschoolofsocialwelfare | 
graddeptsciencematheducation | 
ugprogramtheaterandperformancestudies |

ugdeptmedievalstudies-banner | 
ugprogramtheaterandperformancestudies-banner | 
graddeptsciencetechnologystudies |

gradprogramspecialeducation | 
graddeptslaviclanguagesliteratures | 
ugdeptinterdisciplinarystudies-banner |

graddeptsociology | 
gradprogramstatistics | 
ugprogramtoxicology |

ugprogramtoxicology-banner | 
gradprogramtranslationalmedicine | 
ugdeptanthropology |

ugprogramturkish | 
ugprogramturkish-banner | 
ugprogramurbanstudies |

gradprogramtranslationalmedicine-banner | -thumb.jpg)
gradprogramtranslationalmedicine(jointwithucsf) | 
ugprogramurbanstudies-banner |

ugdeptspanishandportuguese-banner | 
languages | 
gradprogramurbandesign |

gradprogramvisionscience | 
graddeptsociologyanddemography | 
graddeptsouthandsoutheastasianstudies |

graddeptspanishportuguese | 
gradprogramwomengendersexuality | 
graddeptstatistics |

ugdeptreligiousstudies-banner | 
graddepturbandesign | 
graddeptvisionscience |

graddeptwomengendersexuality | 
ugdepttheaterdanceandperformancestudies-banner | 
ugprogramrhetoric-banner |

ugdeptrhetoric-banner | 
graddeptrhetoric-banner | 
gradprogramrhetoric-banner |

gradprogramlinguistics-banner | 
gradprogramartpractice | 
gradprogramearthplanetaryscience-banner |

ugprogramcivilengineering-banner | 
graddeptcityandregionalplanning-banner | 
graddeptlandscapearchitectureenvironmentalplanning-banner |

gradprogramcityregionalplanning-banner | 
gradprogramlandscapearchitectureenvironmentalplanning-banner | 
gradprogramurbandesign-banner |

ugprogramarchitecture-banner | 
ugprogrammathematics2-banner | -banner-thumb.jpg)
gradprogramnuclearengineering(masterofengineering)-banner |

graddeptnuclearengineering-banner | 
gradprogrameuropeanstudies | 
ugdepthistory-banner |

ugprogramhistory-banner1 | 
graddeptindustrialengineeringoperationsresearch-banner | 
gradprogramindustrialengineeringoperationsresearch-banner |

ugprogramplanetaryscience-banner | 
ugdeptbioengineering | 
ugprogramappliedmathematics-banner-banner |

graddeptdemography-banner | 
gradprogramdemography-banner | 
ugprogramdemography-banner |

ugprogramreligiousstudies-banner | 
ugprogramrussianlanguage-banner | 
gradprogramcriticaltheory-banner |

gradprogramdevelopmentpractice-banner | 
gradprogramenergyresources-banner | 
gradprogramfinancialengineering-banner |

gradprogramhealthservicespolicyanalysis-banner | 
gradprogrambusinessadministrationphd-banner | 
gradprogramappliedmathematics-banner |

gradprogramenglish-banner | 
gradprogramfolklore-banner | 
gradprogrampoliticalscience-banner |

gradprogramscienceandmathematicseducation-banner | 
gradprogramsociology-banner | 
gradprogramsociologydemography-banner |

graddepthaasschoolofbusiness-banner | 
graddeptcommunicationcomputationstatistics-banner | 
graddeptcomputationalbiology-banner |

ugprogramamericanstudies-banner | 
gradprogramethnicstudies-banner | 
graddeptethnicstudies-banner |

gradprogramgerman-banner | 
graddeptenergysciencetechnology-banner | 
gradprogramjurisprudencesocialpolicy-banner |

graddeptjurisprudencesocialpolicy-banner | 
graddeptlatinamericanstudies-banner | 
graddeptrangemanagement-banner |

gradprogramrangemanagement-banner | 
graddeptsociologyanddemography-banner | 
graddeptsociology-banner |

gradprogramstatistics-banner | 
graddeptnewmedia-banner | 
gradprogramnewmedia-banner |

ugprogramnewmedia-banner | 
grad-african-american-studies | 
grad-agricultural-resource-economics |

grad-american-studies | 
grad-ancient-egyptian-near-eastern-art-archaeology | 
grad-ancient-egyptian-near-eastern-civilizations |

grad-ancient-history-mediterranean-archaeology | 
grad-anthropology | 
grad-applied-language-studies |

grad-applied-mathematics | 
grad-applied-science-technology | 
grad-arabic |

grad-architecture | 
grad-art-history | 
grad-art-practice |

grad-asian-american-diaspora-studies | 
grad-asian-studies | 
grad-asian-studies-china |

grad-asian-studies-japan | 
grad-asian-studies-multi-area | 
grad-astrophysics |

grad-atmospheric-science | 
grad-bioengineering | 
grad-bioengineering-materials-science-engineering-joint-major |

grad-biophysics | 
grad-biostatistics | 
grad-buddhism |

grad-buddhist-studies | 
grad-business-administration | 
grad-business-administration-evening-weekend-mba |

grad-business-administration-full-time-mba | 
grad-business-administration-mba-executives | 
grad-business-administration-phd |

grad-celtic-studies | 
grad-chemical-biology | 
grad-chemical-biomolecular-engineering |

grad-chemical-engineering | 
grad-chemical-engineering-materials-science-joint-major | 
grad-chemical-engineering-nuclear-joint-major |

grad-chemistry | 
grad-chicano-latino-studies | 
grad-chinese |

grad-chinese-language | 
grad-chinese-studies | 
grad-city-planning |

grad-city-regional-planning | 
grad-civil-engineering | 
grad-civil-environmental-engineering |

grad-classical-archaeology | 
grad-classical-civilizations | 
grad-classical-languages |

grad-classics | 
grad-cognitive-science | 
grad-communication-computation-statistics |

grad-comparative-biochemistry | 
grad-comparative-literature | 
grad-comparative-lterature |

grad-computational-biology | 
grad-computational-science-engineering | 
grad-computer-science |

grad-conservation-resource-studies | 
grad-creative-writing | 
grad-critical-theory |

grad-czech-polish-bosnian-croatian-serbian-language-literature | 
grad-dance-performance-studies | 
grad-demography |

grad-development-engineering | 
grad-development-practice | 
grad-development-studies |

grad-disability-studies | 
grad-dutch | 
grad-dutch-studies |

grad-earth-planetary-science | 
grad-economics | 
grad-education |

grad-electrical-engineering-computer-sciences | 
grad-electrical-engineering-computer-sciences-materials | 
grad-electrical-engineering-computer-sciences-nuclear-joint-major |

grad-endocrinology | 
grad-energy-engineering | 
grad-energy-resources |

grad-energy-science-technology | 
grad-engineering-math-statistics | 
grad-engineering-physics |

grad-english | 
grad-environmental-design-urbanism-developing-countries | 
grad-environmental-earth-science |

grad-environmental-economics-policy | 
grad-environmental-engineering | 
grad-environmental-engineering-science |

grad-environmental-health-sciences | 
grad-environmental-science-policy-management | 
grad-environmental-sciences |

grad-epidemiology | 
grad-ethnic-studies | 
grad-european-studies |

grad-film | 
grad-financial-engineering | 
grad-folklore |

grad-forestry | 
grad-forestry-natural-resources | 
grad-french |

grad-french-civilization | 
grad-french-language-studies | 
grad-french-literature |

grad-gender-womens-studies | 
grad-genetics-plant-biology | 
grad-geoengineering |

grad-geography | 
grad-geology | 
grad-geophysics |

grad-geospatial-information-science-technology | 
grad-geosystems | 
grad-german |

grad-global-metropolitan-studies | 
grad-global-poverty-practice | 
grad-greek |

grad-health-medical-sciences-program | 
grad-health-services-policy-analysis | 
grad-hebrew |

grad-hispanic-languages-bilingual-issues | 
grad-hispanic-languages-literatures | 
grad-history |

grad-history-built-environment | 
grad-human-rights-interdisciplinary | 
grad-iberian-language-literature |

grad-industrial-engineering | 
grad-industrial-engineering-operations-research | 
grad-infectious-diseases-immunity |

grad-information-data-science | 
grad-information-management-systems | 
grad-information-management-systems-masters |

grad-integrated-circuits | 
grad-integrative-biology | 
grad-interdisciplinary-studies |

grad-italian-studies | 
grad-japanese | 
grad-japanese-language |

grad-japanese-studies | 
grad-jewish-studies | 
grad-journalism |

grad-jurisprudence-social-policy | 
grad-korean-language | 
grad-korean-studies |

grad-landscape-architecture | 
grad-landscape-architecture-environmental-planning | 
grad-latin |

grad-latin-american-literatures | 
grad-latin-american-studies | 
grad-law |

grad-legal-studies | 
grad-lesbian-gay-bisexual-transgender-studies | 
grad-linguistics |

grad-logic-methodology-science | 
grad-luso-brazilian-language-literature | 
grad-marine-science |

grad-materials-science-engineering | 
grad-materials-science-engineering-mechanical-joint-major | 
grad-materials-science-engineering-nuclear-joint-major |

grad-mathematics | 
grad-mechanical-engineering | 
grad-mechanical-engineering-nuclear |

grad-media-studies | 
grad-medical-anthropology | 
grad-medieval-studies |

grad-metabolic-biology | 
grad-microbial-biology | 
grad-microbiology |

grad-middle-eastern-studies | 
grad-molecular-cell-biology | 
grad-molecular-cell-biology-biochemistry |

grad-molecular-cell-biology-developmental | 
grad-molecular-cell-biology-genetics | 
grad-molecular-cell-biology-immunology |

grad-molecular-cell-biology-neurobiology | 
grad-molecular-environmental-biology | 
grad-molecular-toxicology |

grad-music | 
grad-nanoscale-science-engineering | 
grad-native-american-studies |

grad-near-eastern-civilizations | 
grad-near-eastern-languages-literatures | 
grad-near-eastern-studies |

grad-neuroscience | 
grad-new-media | 
grad-nuclear-engineering |

grad-nutritional-science | 
grad-operations-research-management-science | 
grad-optometry |

grad-peace-conflict-studies | 
grad-performance-studies | 
grad-persian |

grad-philosophy | 
grad-physics | 
grad-planetary-science |

grad-plant-biology | 
grad-political-economy | 
grad-political-science |

grad-practice-art | 
grad-psychology | 
grad-public-health |

grad-public-policy | 
grad-range-management | 
grad-religious-studies |

grad-renaissance-early-modern | 
grad-rhetoric | 
grad-romance-languages-literatures |

grad-russian-language | 
grad-russian-language-literature-culture | 
grad-russian-literature |

grad-scandinavian | 
grad-science-mathematics-education | 
grad-science-technology-studies |

grad-slavic-languages-literatures | 
grad-social-cultural-factors-environmental-design | 
grad-socialwelfare |

grad-social-welfare | 
grad-society-environment | 
grad-sociology |

grad-sociology-demography | 
grad-south-southeast-asian-studies | 
grad-spanish-language-literature |

grad-spanish-linguistics | 
grad-special-education | 
grad-statistics |

grad-structural-engineering | 
grad-sustainable-environmental-design | 
grad-theater-performance-studies |

grad-toxicology | 
grad-translational-medicine | 
grad-turkish |

grad-urban-design | 
grad-urban-studies | 
grad-vision-science |

grad-women-gender-sexuality | 
ugrad-african-american-studies | 
ugrad-agricultural-resource-economics |

ugrad-american-studies | 
ugrad-ancient-egyptian-near-eastern-art-archaeology | 
ugrad-ancient-egyptian-near-eastern-civilizations |

ugrad-ancient-history-mediterranean-archaeology | 
ugrad-anthropology | 
ugrad-applied-language-studies |

ugrad-applied-mathematics | 
ugrad-applied-science-technology | 
ugrad-arabic |

ugrad-architecture | 
ugrad-art-history | 
ugrad-art-practice |

ugrad-asian-american-diaspora-studies | 
ugrad-asian-studies | 
ugrad-asian-studies-china |

ugrad-asian-studies-japan | 
ugrad-asian-studies-multi-area | 
ugrad-astrophysics |

ugrad-atmospheric-science | 
ugrad-bioengineering | 
ugrad-bioengineering-materials-science-engineering-joint-major |

ugrad-biophysics | 
ugrad-biostatistics | 
ugrad-buddhism |

ugrad-buddhist-studies | 
ugrad-business-administration | 
ugrad-business-administration-evening-weekend-mba |

ugrad-business-administration-full-time-mba | 
ugrad-business-administration-mba-executives | 
ugrad-business-administration-phd |

ugrad-celtic-studies | 
ugrad-chemical-biology | 
ugrad-chemical-biomolecular-engineering |

ugrad-chemical-engineering | 
ugrad-chemical-engineering-materials-science-joint-major | 
ugrad-chemical-engineering-nuclear-joint-major |

ugrad-chemistry | 
ugrad-chicano-latino-studies | 
ugrad-chinese |

ugrad-chinese-language | 
ugrad-chinese-studies | 
ugrad-city-planning |

ugrad-city-regional-planning | 
ugrad-civil-engineering | 
ugrad-civil-environmental-engineering |

ugrad-classical-archaeology | 
ugrad-classical-civilizations | 
ugrad-classical-languages |

ugrad-classics | 
ugrad-cognitive-science | 
ugrad-communication-computation-statistics |

ugrad-comparative-biochemistry | 
ugrad-comparative-literature | 
ugrad-computational-biology |

ugrad-computational-science-engineering | 
ugrad-computer-science | 
ugrad-conservation-resource-studies |

ugrad-creative-writing | 
ugrad-critical-theory | 
ugrad-czech-polish-bosnian-croatian-serbian-language-literature |

ugrad-dance-performance-studies | 
ugrad-demography | 
ugrad-development-engineering |

ugrad-development-practice | 
ugrad-development-studies | 
ugrad-disability-studies |

ugrad-dutch | 
ugrad-dutch-studies | 
ugrad-earth-planetary-science |

ugrad-east-asian-religion-thought-culture | 
ugrad-economics | 
ugrad-education |

ugrad-electrical-engineering-computer-sciences | 
ugrad-electrical-engineering-computer-sciences-materials | 
ugrad-electrical-engineering-computer-sciences-nuclear-joint-major |

ugrad-endocrinology | 
ugrad-energy-engineering | 
ugrad-energy-resources |

ugrad-energy-science-technology | 
ugrad-engineering-math-statistics | 
ugrad-engineering-physics |

ugrad-english | 
ugrad-environmental-design-and-urbanism-in-developing-countries | 
ugrad-environmental-design-urbanism-developing-countries |

ugrad-environmental-earth-science | 
ugrad-environmental-economics-policy | 
ugrad-environmental-engineering |

ugrad-environmental-engineering-science | 
ugrad-environmental-health-sciences | 
ugrad-environmental-science-policy-management |

ugrad-environmental-sciences | 
ugrad-epidemiology | 
ugrad-ethnic-studies |

ugrad-film | 
ugrad-financial-engineering | 
ugrad-folklore |

ugrad-food-systems | 
ugrad-forestry | 
ugrad-forestry-natural-resources |

ugrad-french | 
ugrad-french-civilization | 
ugrad-french-language-studies |

ugrad-french-literature | 
ugrad-gender-and-womens-studies | 
ugrad-gender-womens-studies |

ugrad-genetics-plant-biology | 
ugrad-geoengineering | 
ugrad-geography |

ugrad-geology | 
ugrad-geophysics | 
ugrad-geospatial-information-science-technology |

ugrad-geosystems | 
ugrad-german | 
ugrad-global-metropolitan-studies |

ugrad-global-poverty-practice | 
ugrad-greek | 
ugrad-health-medical-sciences-program |

ugrad-health-services-policy-analysis | 
ugrad-hebrew | 
ugrad-hispanic-languages-bilingual-issues |

ugrad-hispanic-languages-literatures | 
ugrad-history | 
ugrad-history-built-environment |

ugrad-human-rights-interdisciplinary | 
ugrad-iberian-language-literature | 
ugrad-industrial-engineering |

ugrad-industrial-engineering-operations-research | 
ugrad-infectious-diseases-immunity | 
ugrad-information-data-science |

ugrad-information-management-systems | 
ugrad-integrated-circuits | 
ugrad-integrative-biology |

ugrad-interdisciplinary-studies | 
ugrad-italian-studies | 
ugrad-japanese |

ugrad-japanese-language | 
ugrad-japanese-studies | 
ugrad-jewish-studies |

ugrad-journalism | 
ugrad-jurisprudence-social-policy | 
ugrad-korean-language |

ugrad-korean-studies | 
ugrad-landscape-architecture | 
ugrad-landscape-architecture-environmental-planning |

ugrad-latin | 
ugrad-latin-american-literatures | 
ugrad-latin-american-studies |

ugrad-law | 
ugrad-legal-studies | 
ugrad-lesbian-gay-bisexual-transgender-studies |

ugrad-linguistics | 
ugrad-logic-methodology-science | 
ugrad-luso-brazilian-language-literature |

ugrad-marine-science | 
ugrad-materials-science-engineering | 
ugrad-materials-science-engineering-mechanical-joint-major |

ugrad-materials-science-engineering-nuclear-joint-major | 
ugrad-mathematics | 
ugrad-mechanical-engineering |

ugrad-mechanical-engineering-nuclear | 
ugrad-media-studies | 
ugrad-medical-anthropology |

ugrad-medieval-studies | 
ugrad-metabolic-biology | 
ugrad-microbial-biology |

ugrad-microbiology | 
ugrad-middle-eastern-studies | 
ugrad-molecular-cell-biology |

ugrad-molecular-cell-biology-biochemistry | 
ugrad-molecular-cell-biology-developmental | 
ugrad-molecular-cell-biology-genetics |

ugrad-molecular-cell-biology-immunology | 
ugrad-molecular-cell-biology-neurobiology | 
ugrad-molecular-environmental-biology |

ugrad-molecular-toxicology | 
ugrad-music | 
ugrad-nanoscale-science-engineering |

ugrad-native-american-studies | 
ugrad-near-eastern-civilizations | 
ugrad-near-eastern-languages-literatures |

ugrad-near-eastern-studies | 
ugrad-neuroscience | 
ugrad-new-media |

ugrad-nuclear-engineering | 
ugrad-nutritional-science | 
ugrad-operations-research-management-science |

ugrad-optometry | 
ugrad-peace-conflict-studies | 
ugrad-performance-studies |

ugrad-persian | 
ugrad-philosophy | 
ugrad-physics |

ugrad-planetary-science | 
ugrad-plant-biology | 
ugrad-political-economy |

ugrad-political-science | 
ugrad-practice-art | 
ugrad-psychology |

ugrad-public-health | 
ugrad-public-policy | 
ugrad-range-management |

ugrad-religious-studies | 
ugrad-renaissance-early-modern | 
ugrad-rhetoric |

ugrad-romance-languages-literatures | 
ugrad-russian-language | 
ugrad-russian-language-literature-culture |

ugrad-russian-literature | 
ugrad-scandinavian | 
ugrad-science-math-education |

ugrad-science-mathematics-education | 
ugrad-science-technology-studies | 
ugrad-slavic-languages-literatures |

ugrad-social-cultural-factors-environmental-design | 
ugrad-socialwelfare | 
ugrad-social-welfare |

ugrad-society-environment | 
ugrad-sociology | 
ugrad-sociology-demography |

ugrad-south-southeast-asian-studies | 
ugrad-spanish-language-literature | 
ugrad-spanish-linguistics |

ugrad-special-education | 
ugrad-statistics | 
ugrad-structural-engineering |

ugrad-sustainable-design | 
ugrad-sustainable-environmental-design | 
ugrad-theater-performance-studies |

ugrad-toxicology | 
ugrad-translational-medicine | 
ugrad-turkish |

ugrad-urban-design | 
ugrad-urban-studies | 
ugrad-vision-science |

ugrad-women-gender-sexuality | 
ugrad-african-american-studies-popup | 
ugrad-american-studies-popup |

ugrad-ancient-egyptian-near-eastern-art-archaeology-popup | 
ugrad-ancient-egyptian-near-eastern-civilizations-popup | 
ugrad-anthropology-popup |

ugrad-applied-language-studies-popup | 
ugrad-applied-mathematics-popup | 
ugrad-arabic-popup |

ugrad-architecture-popup | 
ugrad-art-history-popup | 
ugrad-art-practice-popup |

ugrad-asian-american-diaspora-studies-popup | 
ugrad-asian-studies-china-popup | 
ugrad-asian-studies-japan-popup |

ugrad-asian-studies-multi-area-popup | 
ugrad-astrophysics-popup | 
ugrad-atmospheric-science-popup |

ugrad-bioengineering-materials-science-engineering-joint-major-popup | 
ugrad-bioengineering-popup | 
ugrad-buddhism-popup |

ugrad-business-administration-popup | 
ugrad-celtic-studies-popup | 
ugrad-chemical-biology-popup |

ugrad-chemical-engineering-materials-science-joint-major-popup | 
ugrad-chemical-engineering-nuclear-joint-major-popup | 
ugrad-chemical-engineering-popup |

ugrad-chemistry-popup | 
ugrad-chicano-latino-studies-popup | 
ugrad-chinese-language-popup |

ugrad-chinese-studies-popup | 
ugrad-city-planning-popup | 
ugrad-civil-engineering-popup |

ugrad-classical-civilizations-popup | 
ugrad-classical-languages-popup | 
ugrad-cognitive-science-popup |

ugrad-comparative-literature-popup | 
ugrad-computer-science-popup | 
ugrad-conservation-resource-studies-popup |

ugrad-creative-writing-popup | 
ugrad-czech-polish-bosnian-croatian-serbian-language-literature-popup | 
ugrad-dance-performance-studies-popup |

ugrad-demography-popup | 
ugrad-development-studies-popup | 
ugrad-disability-studies-popup |

ugrad-dutch-studies-popup | 
ugrad-east-asian-religion-thought-culture-popup | 
ugrad-economics-popup |

ugrad-education-popup | 
ugrad-electrical-engineering-computer-sciences-materials-popup | 
ugrad-electrical-engineering-computer-sciences-nuclear-joint-major-popup |

ugrad-electrical-engineering-computer-sciences-popup | 
ugrad-energy-engineering-popup | 
ugrad-energy-resources-popup |

ugrad-engineering-math-statistics-popup | 
ugrad-engineering-physics-popup | 
ugrad-english-popup |

ugrad-environmental-design-urbanism-developing-countries-popup | 
ugrad-environmental-earth-science-popup | 
ugrad-environmental-economics-policy-popup |

ugrad-environmental-engineering-popup | 
ugrad-environmental-engineering-science-popup | 
ugrad-environmental-sciences-popup |

ugrad-ethnic-studies-popup | 
ugrad-film-popup | 
ugrad-food-systems-popup |

ugrad-forestry-natural-resources-popup | 
ugrad-french-civilization-popup | 
ugrad-french-language-studies-popup |

ugrad-french-literature-popup | 
ugrad-french-popup | 
ugrad-gender-womens-studies-popup |

ugrad-genetics-plant-biology-popup | 
ugrad-geography-popup | 
ugrad-geology-popup |

ugrad-geophysics-popup | 
ugrad-geospatial-information-science-technology-popup | 
ugrad-geosystems-popup |

ugrad-german-popup | 
ugrad-global-poverty-practice-popup | 
ugrad-greek-popup |

ugrad-hebrew-popup | 
ugrad-hispanic-languages-bilingual-issues-popup | 
ugrad-history-built-environment-popup |

ugrad-history-popup | 
ugrad-human-rights-interdisciplinary-popup | 
ugrad-iberian-language-literature-popup |

ugrad-industrial-engineering-operations-research-popup | 
ugrad-integrative-biology-popup | 
ugrad-interdisciplinary-studies-popup |

ugrad-italian-studies-popup | 
ugrad-japanese-language-popup | 
ugrad-japanese-studies-popup |

ugrad-jewish-studies-popup | 
ugrad-korean-language-popup | 
ugrad-korean-studies-popup |

ugrad-landscape-architecture-popup | 
ugrad-latin-american-literatures-popup | 
ugrad-latin-american-studies-popup |

ugrad-latin-popup | 
ugrad-legal-studies-popup | 
ugrad-lesbian-gay-bisexual-transgender-studies-popup |

ugrad-linguistics-popup | 
ugrad-luso-brazilian-language-literature-popup | 
ugrad-marine-science-popup |

ugrad-materials-science-engineering-mechanical-joint-major-popup | 
ugrad-materials-science-engineering-nuclear-joint-major-popup | 
ugrad-materials-science-engineering-popup |

ugrad-mathematics-popup | 
ugrad-mechanical-engineering-nuclear-popup | 
ugrad-mechanical-engineering-popup |

ugrad-media-studies-popup | 
ugrad-medieval-studies-popup | 
ugrad-microbial-biology-popup |

ugrad-middle-eastern-studies-popup | 
ugrad-molecular-cell-biology-biochemistry-popup | 
ugrad-molecular-cell-biology-developmental-popup |

ugrad-molecular-cell-biology-genetics-popup | 
ugrad-molecular-cell-biology-immunology-popup | 
ugrad-molecular-cell-biology-neurobiology-popup |

ugrad-molecular-environmental-biology-popup | 
ugrad-music-popup | 
ugrad-native-american-studies-popup |

ugrad-near-eastern-civilizations-popup | 
ugrad-near-eastern-languages-literatures-popup | 
ugrad-new-media-popup |

ugrad-nuclear-engineering-popup | 
ugrad-nutritional-science-popup | 
ugrad-operations-research-management-science-popup |

ugrad-peace-conflict-studies-popup | 
ugrad-persian-popup | 
ugrad-philosophy-popup |

ugrad-physics-popup | 
ugrad-planetary-science-popup | 
ugrad-political-economy-popup |

ugrad-political-science-popup | 
ugrad-psychology-popup | 
ugrad-public-health-popup |

ugrad-public-policy-popup | 
ugrad-religious-studies-popup | 
ugrad-rhetoric-popup |

ugrad-russian-language-literature-culture-popup | 
ugrad-russian-language-popup | 
ugrad-russian-literature-popup |

ugrad-scandinavian-popup | 
ugrad-science-math-education-popup | 
ugrad-slavic-languages-literatures-popup |

ugrad-social-cultural-factors-environmental-design-popup | 
ugrad-socialwelfare-popup | 
ugrad-society-environment-popup |

ugrad-sociology-popup | 
ugrad-south-southeast-asian-studies-popup | 
ugrad-spanish-language-literature-popup |

ugrad-spanish-linguistics-popup | 
ugrad-statistics-popup | 
ugrad-structural-engineering-popup |

ugrad-sustainable-design-popup | 
ugrad-sustainable-environmental-design-popup | 
ugrad-theater-performance-studies-popup |

ugrad-toxicology-popup | 
ugrad-turkish-popup | 
ugrad-urban-studies-popup |

grad-african-american-studies-popup | 
grad-agricultural-resource-economics-popup | 
grad-ancient-history-mediterranean-archaeology-popup |

grad-anthropology-popup | 
grad-applied-mathematics-popup | 
grad-applied-science-technology-popup |

grad-architecture-popup | 
grad-art-history-popup | 
grad-asian-studies-popup |

grad-astrophysics-popup | 
grad-bioengineering-popup | 
grad-biophysics-popup |

grad-biostatistics-popup | 
grad-buddhist-studies-popup | 
grad-business-administration-evening-weekend-mba-popup |

grad-business-administration-full-time-mba-popup | 
grad-business-administration-mba-executives-popup | 
grad-business-administration-phd-popup |

grad-chemical-biomolecular-engineering-popup | 
grad-chemistry-popup | 
grad-chinese-popup |

grad-city-regional-planning-popup | 
grad-civil-environmental-engineering-popup | 
grad-classical-archaeology-popup |

grad-classics-popup | 
grad-communication-computation-statistics-popup | 
grad-comparative-biochemistry-popup |

grad-comparative-literature-popup | 
grad-computational-biology-popup | 
grad-computational-science-engineering-popup |

grad-computer-science-popup | 
grad-critical-theory-popup | 
grad-demography-popup |

grad-development-engineering-popup | 
grad-development-practice-popup | 
grad-dutch-popup |

grad-earth-planetary-science-popup | 
grad-economics-popup | 
grad-education-popup |

grad-electrical-engineering-computer-sciences-popup | 
grad-endocrinology-popup | 
grad-energy-resources-popup |

grad-energy-science-technology-popup | 
grad-english-popup | 
grad-environmental-health-sciences-popup |

grad-environmental-science-policy-management-popup | 
grad-epidemiology-popup | 
grad-ethnic-studies-popup |

grad-european-studies-popup | 
grad-film-popup | 
grad-financial-engineering-popup |

grad-folklore-popup | 
grad-forestry-popup | 
grad-french-popup |

grad-geography-popup | 
grad-german-popup | 
grad-global-metropolitan-studies-popup |

grad-health-medical-sciences-program-popup | 
grad-health-services-policy-analysis-popup | 
grad-hispanic-languages-literatures-popup |

grad-history-popup | 
grad-industrial-engineering-popup | 
grad-infectious-diseases-immunity-popup |

grad-information-data-science-popup | 
grad-information-management-systems-masters-popup | 
grad-information-management-systems-popup |

grad-integrated-circuits-popup | 
grad-integrative-biology-popup | 
grad-italian-studies-popup |

grad-japanese-popup | 
grad-jewish-studies-popup | 
grad-journalism-popup |

grad-jurisprudence-social-policy-popup | 
grad-landscape-architecture-environmental-planning-popup | 
grad-latin-american-studies-popup |

grad-law-popup | 
grad-linguistics-popup | 
grad-logic-methodology-science-popup |

grad-materials-science-engineering-popup | 
grad-mathematics-popup | 
grad-mechanical-engineering-popup |

grad-medical-anthropology-popup | 
grad-medieval-studies-popup | 
grad-metabolic-biology-popup |

grad-microbiology-popup | 
grad-molecular-cell-biology-popup | 
grad-molecular-toxicology-popup |

grad-music-popup | 
grad-nanoscale-science-engineering-popup | 
grad-near-eastern-studies-popup |

grad-neuroscience-popup | 
grad-new-media-popup | 
grad-nuclear-engineering-popup |

grad-optometry-popup | 
grad-performance-studies-popup | 
grad-philosophy-popup |

grad-physics-popup | 
grad-plant-biology-popup | 
grad-political-science-popup |

grad-practice-art-popup | 
grad-psychology-popup | 
grad-public-health-popup |

grad-public-policy-popup | 
grad-range-management-popup | 
grad-renaissance-early-modern-popup |

grad-rhetoric-popup | 
grad-romance-languages-literatures-popup | 
grad-scandinavian-popup |

grad-science-mathematics-education-popup | 
grad-science-technology-studies-popup | 
grad-slavic-languages-literatures-popup |

grad-social-welfare-popup | 
grad-sociology-demography-popup | 
grad-sociology-popup |

grad-south-southeast-asian-studies-popup | 
grad-special-education-popup | 
grad-statistics-popup |

grad-translational-medicine-popup | 
grad-urban-design-popup | 
grad-vision-science-popup |

grad-women-gender-sexuality-popup | 
study-abroad | 
berkeley-study-abroad |

ugdeptenglish-banner | 
ugrad-journalism-popup | 
gradprogrampsychology-banner |

ugprogrampublicpolicy-banner | 
graddeptmicrobiology-banner | 
ugdeptphysicaleducation-banner |

ugdeptitalianstudies-banner | 
graddeptitalianstudies-banner | 
ugprogramitalianstudies-banner |

ugdeptgeography-banner | 
ugprogramrussianlanguageliteratureandculture-banner | 
ugdeptafricanamericanstudies-banner |

graddeptafricanamericanstudies-banner | 
ugdeptnuclearengineering-banner | 
ugdeptchemistry-banner |

graddeptchemicalandbiomoleularengineering-banner | 
ugdeptartpracticeof-banner | 
graddeptanthropology-banner |

ugprogrammusic-banner | 
gradprogramartpractice-banner | 
graddeptarthistoryof-banner |

ugdeptarthistory-banner | 
graddeptastronomy-banner | 
ugdeptastronomy-banner |

graddeptcomputationalscienceengineering-banner | 
gradprogramphilosophy-banner | 
ugprogrammechanicalengineering-banner |

ugdeptjewishstudiescenterfor-banner | 
graddeptschoolofsocialwelfare-banner | 
ugprogramsocialwelfare-banner |

graddeptfolklore-banner | 
ugdeptearthandplanetaryscience-banner | 
ugprogramfrench-banner |

ugdeptstatistics-banner | 
ugprogramstatistics-banner | 
ugprogramsocietyandenvironment-banner |

ugprogramenvironmentalsciences-banner | 
ugdeptengineeringscience-banner | 
gradprogramphilosophy-banner-banner |

languages-banner | 
ugprogrameconomics-banner | 
ugdeptdevelopmentstudies-banner |

ugdeptphysics-banner | 
graddeptbuddhiststudies-banner | 
ugdeptinternationalareastudies-banner |

ugradprogrampsychology-banner | 
ugbuddhiststudies-banner | 
ugprogramcelticstudies-banner |

ugprogramchineselanguage-banner | 
ugdeptglobalpovertyandpractice-banner | 
ugdeptmediastudies-banner |

graddeptmedicalanthropology-banner | 
ugdeptmedievalstudies-banner | 
graddeptmedievalstudies-banner |

ugdeptmiddleeasternstudies-banner | 
ugdeptpeaceandconflictstudies-banner | 
ugdeptplantandmicrobialbiology-banner |

ugdeptpoliticaleconomy-banner | 
gradprogramrenaissanceearlymodernstudies-banner | 
ugprogramtoxicology-banner |

ugprogramtibetan-banner | 
ugprogramarthistoryof-banner | 
ugdeptmolecularandcellbiology-banner |

ugprogramgeography-banner | 
graddeptsciencetechnologystudies-banner | 
gradprogramfrench-banner |

graddeptscandinavianlanguagesliteratures-banner | 
ugprogramphilosophy-banner | 
ugprogrammaterialsscienceandengineering-banner |

ugprogramfilm-banner | 
ugdeptphilosophy-banner | 
graddeptphilosophy-banner |

ugprogramindustrialengineeringandoperationsresearchandbusinessadministration-banner | 
ugrad-electrical-engineering-computer-sciences-business-administration-popup | 
ugrad-industrial-engineering-operations-research-business-administration-popup |

ugrad-industrial-engineering-operations-research-business-administration | 
ugrad-electrical-engineering-computer-sciences-business-administration | 
degreeprogramsvideo |

ugprogramelectricalengineeringcomputersciencesbusinessadministration | 
grad-art | 
ugprogramturkish-banner |

ugprogramglobalstudies-banner | 
footerdirkswelcome | 
ugprogramappliedlanguagestudies |

ugprogramappliedlanguagestudies-banner | 
ugprogramappliedmathematics | 
ugprogramappliedmathematics-banner |

ugprogramarabic | 
ugprogramarabic-banner | 
ugprogramarchitecture |

ugprogramarthistoryof | 
ugprogramartpractice | 
ugprogramartpracticeof |

ugprogramasianamericanandasiandiasporastudies | 
ugprogramasianamericanandasiandiasporastudies-banner | 
ugprogramasianstudieschina |

ugprogramasianstudieschina-banner | 
ugprogramasianstudiesjapan | 
ugprogramasianstudiesjapan-banner |

ugprogramastrophysics | 
ugprogramasianstudiesmultiarea | 
ugprogramastrophysics-banner |

ugprogramatmosphericscience | 
ugprogramatmosphericscience-banner | 
ugprogrambioengineering |

ugprogrambioengineeringmaterialsscienceandengineeringjointmajor | 
ugprogrambioengineeringmaterialsscienceandengineeringjointmajor-banner | 
ugprogrambuddhism |

ugprogrambuddhism-banner | 
ugprogrambusinessadmin | 
ugprogramcelticstudies |

ugprogramchemicalbiology | 
ugprogramchemicalbiology-banner | 
ugprogramchemicalengineering |

ugprogramchemicalengineering-banner | 
ugprogramchemicalengineeringmaterialsscienceandengineeringjointmajor | 
ugprogramchemicalengineeringmaterialsscienceandengineeringjointmajor-banner |

ugprogramchemicalengineeringnuclear | 
ugprogramchemicalengineeringnuclearengineeringjointmajor | 
ugprogramchemicalengineeringnuclearengineeringjointmajor-banner |

ugprogramchemistry | 
ugprogramchemistry-banner | 
ugprogramchicanolatinostudies |

ugprogramchicanolatinostudies-banner | 
ugprogramchineselanguage | 
ugprogramchinesestudies |

ugprogramchinesestudies-banner | 
ugprogramcityandregionalplanning | 
ugprogramcityandregionalplanning-banner |

ugprogramcivilengineering | 
ugprogramclassicalcivilizations | 
ugprogramclassicalcivilizations-banner |

ugprogramclassicallanguages | 
ugprogramclassicallanguages-banner | 
ugprogramcognitivescience |

ugprogramcognitivescience-banner | 
ugprogramcomparativeliterature | 
ugprogramcomparativeliterature-banner |

ugprogramcomputerscience | 
ugprogramcomputerscience-banner | 
ugprogramconservationandresourcestudies |

ugprogramconservationandresourcestudies-banner | 
ugprogramcreativewriting | 
ugprogramcreativewriting-banner |

ugprogramczechpolishorbosniancroatianserbianlanguageandliterature | 
ugprogramczechpolishorbosniancroatianserbianlanguageandliterature-banner | 
ugprogramdanceandperformancestudies |

ugprogramdanceandperformancestudies-banner | 
ugprogramdevelopmentstudies | 
ugprogramdevelopmentstudies-banner |

ugprogramdisabilitystudies | 
ugprogramdisabilitystudies-banner | 
ugprogramdutchstudies |

ugprogramdutchstudies-banner | 
ugprogramdutchstudies-banner-1 | 
ugprogrameastasianreligionthoughtandculture |

ugprogrameastasianreligionthoughtandculture-banner | 
ugprogrameconomics | 
ugprogrameducation |

ugprogramelectricalengineeringandcomputersciences | 
ugprogramelectricalengineeringandcomputersciences-banner | 
ugprogramelectricalengineeringandcomputersciencesmaterialsscienceandengineeringjointmajor |

ugprogramelectricalengineeringandcomputersciencesmaterialsscienceandengineeringjointmajor-banner | 
ugprogramelectricalengineeringandcomputersciencesnuclearengineeringjointmajor | 
ugprogramelectricalengineeringandcomputersciencesnuclearengineeringjointmajor-banner |

ugprogramenergyandresources | 
ugprogramenergyandresources-banner | 
ugprogramenergyengineering |

ugprogramenergyengineering-banner | 
ugprogramengineeringmathandstatistics | 
ugprogramengineeringmathandstatistics-banner |

ugprogramengineeringphysics | 
ugprogramengineeringphysics-banner | 
ugprogramenglish |

ugprogramenglish-banner | 
ugprogramenviornmentaldesignandurbanismindevelopingcountries | 
ugprogramenviornmentaldesignandurbanismindevelopingcountries-banner |

ugprogramenvironmentalearthscience | 
ugprogramenvironmentalearthscience-banner | 
ugprogramenvironmentaleconomicsandpolicy |

ugprogramenvironmentaleconomicsandpolicy-banner | 
ugprogramenvironmentalengineering | 
ugprogramenvironmentalengineering-banner |

ugprogramenvironmentalengineeringscience | 
ugprogramenvironmentalengineeringscience-banner | 
ugprogramenvironmentalsciences |

ugprogramethnicstudies | 
ugprogramethnicstudies-banner | 
ugprogramfilm |

ugprogramfoodsystems | 
ugprogramforestryandnaturalresources | 
ugprogramforestryandnaturalresources-banner |

ugprogramfrench | 
ugprogramfrenchcivilization | 
ugprogramfrenchcivilization-banner |

ugprogramfrenchlanguagestudies | 
ugprogramfrenchlanguagestudies-banner | 
ugprogramfrenchliterature |

ugprogramfrenchliterature-banner | 
ugprogramgenderandwomen'sstudies | 
ugprogramgenderandwomen'sstudies-banner |

ugprogramgeneticsandplantbiology | 
ugprogramgeneticsandplantbiology-banner | 
ugprogramgeoengineering |

ugprogramgeoengineering-banner | 
ugprogramgeography | 
ugprogramgeology |

ugprogramgeology-banner | 
ugprogramgeophysics | 
ugprogramgeophysics-banner |

ugprogramgeospatialinformationscienceandtechnology | 
ugprogramgeospatialinformationscienceandtechnology-banner | 
ugdeptamericanstudies-banner |

ugprogramgerman | 
ugprogramgerman-banner | 
ugprogramglobalpovertyandpractice |

ugdeptanthropology-banner | 
ugprogramglobalpovertyandpractice-banner | 
ugprogramgreek |

ugprogramgreek-banner | 
ugprogramhebrew | 
ugprogramhebrew-banner |

ugprogramhispaniclanguagesandbilingualissues | 
ugprogramhispaniclanguagesandbilingualissues-banner | 
ugprogramhistory |

ugprogramhistory-banner | 
ugprogramhistoryofthebuiltenvironment | 
ugprogramhistoryofthebuiltenvironment-banner |

ugprogramhumanrightsinterdisciplinary | 
ugprogramhumanrightsinterdisciplinary-banner | 
ugprogramhumanrightsinterdisciplinary-banner-1 |

ugprogramiberianlanguageandliterature | 
ugprogramiberianlanguageandliterature-banner | 
ugprogramindustrialengineeringandoperationsresearch |

ugprogramindustrialengineeringandoperationsresearch-banner | 
ugprogramindustrialengineeringandoperationsresearch-banner-1 | 
ugprogramintegrativebiology |

ugprogramintegrativebiology-banner | 
ugprograminterdisciplinarystudies | 
ugprograminterdisciplinarystudies-banner |

ugprogramitalianstudies | 
ugprogramjapaneselanguage | 
ugprogramjapaneselanguage-banner |

ugprogramjapanesestudies | 
ugprogramjapanesestudies-banner | 
ugprogramjewishstudies |

ugprogramjewishstudies-banner | 
ugprogramjournalism | 
ugprogramkoreanlanguage |

ugprogramkoreanlanguage-banner | 
ugprogramkoreanstudies | 
ugprogramkoreanstudies-banner |

ugprogramlandscapearchitecture | 
ugprogramlandscapearchitecture-banner | 
ugprogramlatin |

ugprogramlatin-banner | 
ugprogramlatinamericanliteratures | 
ugprogramlatinamericanliteratures-banner |

ugprogramlatinamericanstudies | 
ugprogramlatinamericanstudies-banner | 
ugprogramlegalstudies |

ugprogramlegalstudies-banner | 
ugprogramlesbiangaybisexualandtransgenderstudies | 
ugprogramlinguistics |

ugprogramlinguistics-banner | 
ugprogramlusobrazilianlanguageandliterature | 
ugprogramlusobrazilianlanguageandliterature-banner |

ugprogrammarinescience | 
ugprogrammarinescience-banner | 
ugprogrammaterialsscienceandengineering |

ugprogrammaterialsscienceandengineeringmechanicalengineeringjointmajor | 
ugprogrammaterialsscienceandengineeringmechanicalengineeringjointmajor-banner | 
ugprogrammaterialsscienceandengineeringnuclearengineeringjointmajor |

ugprogrammaterialsscienceandengineeringnuclearengineeringjointmajor-banner | 
ugprogrammathematics | 
ugprogrammathematics2 |

ugprogrammathematics-banner | 
ugprogrammechanicalengineering | 
ugprogrammechanicalengineeringnuclearengineering |

ugprogrammechanicalengineeringnuclearengineering-banner | 
ugprogrammediastudies | 
ugprogrammedievalstudies |

ugprogrammedievalstudies-banner | 
ugprogrammicrobialbiology | 
ugprogrammicrobialbiology-banner |

ugprogrammiddleeasternstudies | 
ugprogrammiddleeasternstudies-banner | 
ugprogrammolecularandcellbiologybiochemistryandmolecularbiology |

ugprogrammolecularandcellbiologybiochemandmolebio | 
ugprogrammolecularandcellbiologycellanddevelopmentalbiology | 
ugprogrammolecularandcellbiologycellanddevelopmentalbiology-banner |

ugprogrammolecularandcellbiologygeneticsgenomicsanddevelopment | 
ugprogrammolecularandcellbiologygeneticsgenomicsanddevelopment-banner | 
ugprogrammolecularandcellbiologyimmunologyandpathogenesis |

ugprogrammolecularandcellbiologyimmunologyandpathogenesis-banner | 
ugprogrammolecularandcellbiologyneurobiology | 
ugprogrammolecularandcellbiologyneurobiology-banner |

ugprogrammolecularenvironmentalbiology | 
ugprogrammolecularenvironmentalbiology-banner | 
ugprogrammoleculartoxicology |

ugprogrammusic | 
ugprogramnativeamericanstudies | 
ugprogramnativeamericanstudies-banner |

ugprogramneareasterncivilizations | 
ugprogramneareasterncivilizations-banner | 
ugprogramneareasternlanguagesandliteratures |

ugprogramneareasternlanguagesandliteratures-banner | 
ugprogramnuclearengineering | 
ugprogramnuclearengineering-banner |

ugprogramnutritionalscience | 
ugprogramnutritionalscience-banner | 
ugprogramoperationsresearchandmanagementscience |

ugprogramoperationsresearchandmanagementscience-banner | 
ugprogrampeaceandconflictstudies | 
ugprogrampeaceandconflictstudies-banner |

ugprogrampersian | 
ugprogrampersian-banner | 
ugprogramphysics |

ugprogramphysics-banner | 
ugprogrampoliticaleconomy | 
ugprogrampoliticaleconomy-banner |

ugprogrampoliticalscience | 
ugprogrampoliticalscience-banner | 
ugprogrampsychology |

ugprogrampublichealth | 
ugprogrampublichealth-banner | 
ugprogrampublicpolicy |

ugprogrampublicpolicy | 
ugprogramreligiousstudies | 
ugprogramrhetoric |

ugprogramrussianlanguage | 
ugprogramrussianlanguageliteratureandculture | 
ugdeptpeaceandconflictstudies |

ugdeptmedievalstudies | 
ugdeptmiddleeasternstudies | 
ugdeptengineeringscience |

ugdeptmediastudies | 
ugdeptartpracticeof | 
ugdeptbiologygeneral |

graddeptpoliticalscience | 
graddeptpsychology | 
ugprogramrussianliterature |

ugprogramrussianliterature-banner | 
ugprogramscandinavian | 
ugprogramscandinavian-banner |

graddeptearthandplanetaryscience-banner | 
ugprogramscienceandmatheducation | 
ugprogramscienceandmatheducation-banner |

ugprogramslaviclanguagesliteratures | 
ugprogramsocialandculturalfactorsinenviornmentaldesign | 
ugprogramsocialandculturalfactorsinenviornmentaldesign-banner |

ugprogramsocialwelfare | 
ugprogramsocietyandenvironment | 
ugprogramsociology |

ugprogramsociology-banner | 
ugprogramsouthandsoutheastasianstudies | 
ugdeptamericanstudies |

ugdeptfrench-banner | 
ugdepteconomics-banner | 
ugdeptenergyandresources-banner |

graddeptrangemanagement | 
ugdeptfilmandmedia-banner | 
ugdeptbioengineering-banner |

ugdeptelectricalengineeringandcomputersciences-banner | 
ugdeptcivilandenvironmentalengineering-banner | 
ugdeptchemicalandbiomolecularengineering-banner |

ugdeptethnicstudies-banner | 
ugdepteastasianlanguagesandcultures-banner | 
ugdeptenvironmentalsciencepolicyandmanagement-banner |

ugdeptcityandregionalplanning-banner | 
ugdeptagriculturalandresourceeconomics-banner | 
ugdeptarchitecture-banner |

ugdeptcognitivescience-banner | 
ugdeptasianstudies-banner | 
ugdeptclassics-banner |

ugdeptcollegewriting-banner | 
ugdeptdemography-banner | 
ugdeptcomparativeliterature-banner |

ugdeptgenderandwomen'sstudies-banner | 
ugdeptgerman-banner | 
ugdeptlinguistics-banner |

gradprogrammaterialsscienceengineering | 
ugdeptintegrativebiology-banner | 
ugdeptmaterialsscienceandengineering-banner |

ugdeptnutritionalsciencesandtoxicology-banner | 
ugdeptmathematics-banner | 
ugdeptmechanicalengineering-banner |

ugdeptlandscapearchitecture-banner | 
ugdeptlatinamericanstudies-banner | 
ugdeptindustrialengineeringandoperationsresearch-banner |

ugdeptmilitaryaffairs-banner | 
ugdeptmusic-banner | 
ugdeptlegalstudies-banner |

ugdeptneareasternstudies-banner | 
gradprogrammathematics | 
gradprogrammechanicalengineering |

gradprogrammedicalanthropologyjointprogramwithucsf | 
ugdeptpoliticalscience-banner | 
ugdeptundergraduateandinterdisciplinarystudies-banner |

ugdeptsociology-banner | -thumb.jpg)
gradprogrammedicalanthropology(jointprogramwithucsf) | 
ugdeptscandinavian-banner |

ugdeptbiologygeneral-banner | 
gradprogrammedievalstudies | 
gradprogrammetabolicbiology |

gradprogrammetabolicbiology-banner | 
gradprogrammicrobiology | 
gradprogrammolecularandcellbiology |

gradprogrammoleculartoxicology | 
gradprogrammusic | 
gradprogramnanoscalescienceengineering |

gradprogramneareasternstudies | 
gradprogramneuroscience | 
gradprogramnewmedia |
-thumb.jpg)
gradprogramnuclearengineering(masterofengineering) | -thumb.jpg)
gradprogramoptometry(residencyprogram) | 
gradprogramoptometry |

gradprogramperformancestudies | 
ugdeptintegrativebiologyjpg | 
ugprogramspanishlangaugeandliterature |

home | 
gradprogramphilosophy | 
gradprogramphysics |

gradprogramplantbiology | 
gradprogrampoliticalscience | 
gradprogrampsychology |

gradprogrampublichealth | 
gradprogrampublicpolicy | 
graddeptrenaissanceearlymodernstudies |

graddeptrhetoric | 
graddeptromancelanguagesandliteratures | 
ugprogramspanishlangaugeandliterature-banner |

ugprogramspanishlinguistics | 
gradprogramrangemanagement | 
ugprogramspanishlinguistics-banner |

ugbuddhiststudies | 
genderwomenstudies | 
ugprogramstatistics |

ugdeptarchitecture | 
gradprogramrenaissanceearlymodernstudies | 
ugprogramstructuralengineering |

gradprogramrhetoric | 
gradprogramromancelanguagesliteraturesfrench | 
gradprogramromancelanguagesliteraturesitalian |

gradprogramromancelanguagesliteraturesspansih | 
gradprogramscandinavianlanguagesliteratures | 
gradprogramscienceandmathematicseducation |

gradprogramsciencetechnologystudies | 
ugprogramstructuralengineering-banner | 
ugprogramsustainabledesign |

ugprogramsustainabledesign-banner | 
gradprogramslaviclanguagesliteratures | 
gradprogramsocialwelfare |

ugprogramsustainabledesign-banner-banner | 
ugprogramsustainableenvironmentaldesign | 
gradprogramsociology |

gradprogramsociologydemography | 
graddeptscandinavianlanguagesliteratures | 
ugprogramsustainableenvironmentaldesign-banner |

gradprogramsouthandsoutheastasianstudies | 
ugdeptsouthandsoutheastasianstudies | 
graddeptschoolofinformation |

graddeptschoolofoptometry | 
graddeptschoolofpublichealth | 
graddeptschoolofsocialwelfare |

graddeptsciencematheducation | 
ugprogramtheaterandperformancestudies | 
ugprogramtheaterandperformancestudies-banner |

graddeptsciencetechnologystudies | 
gradprogramspecialeducation | 
graddeptslaviclanguagesliteratures |

graddeptsociology | 
gradprogramstatistics | 
ugprogramtoxicology |

gradprogramtranslationalmedicine | 
ugdeptanthropology | 
ugprogramturkish |

ugprogramurbanstudies | 
gradprogramtranslationalmedicine-banner | -thumb.jpg)
gradprogramtranslationalmedicine(jointwithucsf) |

ugprogramurbanstudies-banner | 
ugdeptspanishandportuguese-banner | 
languages |

gradprogramurbandesign | 
gradprogramvisionscience | 
graddeptsociologyanddemography |

graddeptsouthandsoutheastasianstudies | 
graddeptspanishportuguese | 
gradprogramwomengendersexuality |

graddeptstatistics | 
ugdeptreligiousstudies-banner | 
graddepturbandesign |

graddeptvisionscience | 
graddeptwomengendersexuality | 
ugdepttheaterdanceandperformancestudies-banner |

ugprogramrhetoric-banner | 
ugdeptrhetoric-banner | 
graddeptrhetoric-banner |

gradprogramrhetoric-banner | 
gradprogramlinguistics-banner | 
gradprogramartpractice |

gradprogramearthplanetaryscience-banner | 
ugprogramcivilengineering-banner | 
graddeptcityandregionalplanning-banner |

graddeptlandscapearchitectureenvironmentalplanning-banner | 
gradprogramcityregionalplanning-banner | 
gradprogramlandscapearchitectureenvironmentalplanning-banner |

gradprogramurbandesign-banner | 
ugprogramarchitecture-banner | 
ugprogrammathematics2-banner |
-banner-thumb.jpg)
gradprogramnuclearengineering(masterofengineering)-banner | 
graddeptnuclearengineering-banner | 
gradprogrameuropeanstudies |

ugdepthistory-banner | 
ugprogramhistory-banner1 | 
graddeptindustrialengineeringoperationsresearch-banner |

gradprogramindustrialengineeringoperationsresearch-banner | 
ugprogramplanetaryscience-banner | 
ugraddeptbioengineering |

ugprogramappliedmathematics-banner-banner | 
graddeptdemography-banner | 
gradprogramdemography-banner |

ugprogramdemography-banner | 
ugprogramreligiousstudies-banner | 
ugprogramrussianlanguage-banner |

gradprogramcriticaltheory-banner | 
gradprogramdevelopmentpractice-banner | 
gradprogramenergyresources-banner |

gradprogramfinancialengineering-banner | 
gradprogramhealthservicespolicyanalysis-banner | 
gradprogrambusinessadministrationphd-banner |

gradprogramappliedmathematics-banner | 
gradprogramenglish-banner | 
gradprogramfolklore-banner |

gradprogrampoliticalscience-banner | 
gradprogramscienceandmathematicseducation-banner | 
gradprogramsociology-banner |

gradprogramsociologydemography-banner | 
graddepthaasschoolofbusiness-banner | 
graddeptcommunicationcomputationstatistics-banner |

graddeptcomputationalbiology-banner | 
ugprogramamericanstudies-banner | 
gradprogramethnicstudies-banner |

graddeptethnicstudies-banner | 
gradprogramgerman-banner | 
graddeptenergysciencetechnology-banner |

gradprogramjurisprudencesocialpolicy-banner | 
graddeptjurisprudencesocialpolicy-banner | 
graddeptlatinamericanstudies-banner |

graddeptrangemanagement-banner | 
gradprogramrangemanagement-banner | 
graddeptsociologyanddemography-banner |

graddeptsociology-banner | 
gradprogramstatistics-banner | 
graddeptnewmedia-banner |

gradprogramnewmedia-banner | 
ugprogramnewmedia-banner | 
ugprogramgeophysics-17 |

ugprogramgeology-17 | 
ugprogramgeography-17 | 
ugprogramfrench-17 |

ugprogramfilm-17 | 
ugprogramethnicstudies-17 | 
ugprogramenvironmentalearthscience-17 |

ugprogrameconomics-17 | 
ugprogramdisabilitystudies-17 | 
ugdeptdemography-17 |

ugprogramdanceandperformancestudies-17 | 
ugprogramcivilengineering-17 | 
ugprogramchineselanguage-17 |

ugprogramatmosphericscience-17 | 
ugprogramasianamericanandasiandiasporastudies-17 | 
ugprogramatmosphericscience-17-1 |

ugprogramarchitecture-17 | 
ugprogramarabic-17 | 
ugprogramappliedmathematics-17 |

ugprogramgerman-17 | 
ugprogramhumanrightsinterdisciplinary-17 | 
ugprogramindustrialengineeringandoperationsresearch-17 |

ugprograminterdisciplinarystudies-17 | 
ugprogramitalianstudies-17 | 
ugprogramlandscapearchitecture-17 |

ugprogramlatin-17 | 
ugprogrammarinescience-17 | 
ugprogrammaterialsscienceandengineering-17 |

ugprogrammathematics-17 | 
ugprogrammechanicalengineering-17 | 
ugprogrammedievalstudies-17 |

ugprogrammusic-17 | 
ugprogramneareasterncivilizations-17 | 
ugprogramneareasternlanguagesandliteratures-17 |

ugprogramnuclearengineering-17 | 
ugprograminterdisciplinarystudies-17-1 | 
ugprogramnutritionalscience-17 |

ugprogrampeaceandconflictstudies-17 | 
ugprogrampersian-17 | 
ugprogrampublicpolicy-17 |

ugprogramreligiousstudies-17 | 
ugprogramrhetoric-17 | 
ugprogramrussianlanguage-17 |

ugprogramrussianlanguageliteratureandculture-17 | 
ugprogramscienceandmatheducation-17 | 
ugprogramsocietyandenvironment-17 |

ugprogramspanishlinguistics-17 | 
ugprogramstatistics-17 | 
ugprogramsustainabledesign-17 |

ugprogramsustainableenvironmentaldesign-17 | 
ugprogramtheaterandperformancestudies-17 | 
ugprogramturkish-17 |

ugprogramurbanstudies-17 | 
gradprogramafricanamericanstudies-17 | 
gradprogramappliedmathematics-17 |

gradprogramartpractice-17 | 
gradprogrambusinessadministrationeveningweekendmbaprogram-17 | 
gradprogrambusinessadministrationfulltimembaprogram-17 |

gradprogrambusinessadministrationphd-17 | 
gradprogramcityregionalplanning-17 | 
gradprogramcivilandenvironmentalengineering-17 |

gradprogramcriticaltheory-17 | 
gradprogramdemography-17 | 
gradprogramdevelopmentpractice-17 |

gradprogramearthplanetaryscience-17 | 
gradprogramelectricalengineeringcomputersciences-17 | 
gradprogramenergyresources-17 |

gradprogramenglish-17 | 
gradprogramethnicstudies-17 | 
gradprogramfinancialengineering-17 |

gradprogramfolklore-17 | 
gradprogramfrench-17 | 
gradprogramgerman-17 |

gradprogramhealthservicespolicyanalysis-17 | 
gradprogramindustrialengineeringoperationsresearch-17 | 
gradprograminformationanddatascience-17 |

gradprogramjurisprudencesocialpolicy-17 | 
gradprogramlandscapearchitectureenvironmentalplanning-17 | 
gradprogramlinguistics-17 |

gradprogramnewmedia-17 | -17-thumb.jpg)
gradprogramnuclearengineering(masterofengineering)-17 | 
gradprogramphilosophy-banner-17 |

gradprogrampoliticalscience-17 | 
gradprogrampsychology-17 | 
gradprogramrangemanagement-17 |

gradprogramrhetoric-17 | 
gradprogramscienceandmathematicseducation-17 | 
gradprogramsociology-17 |

gradprogramsociologydemography-17 | 
gradprogramstatistics-17 | 
gradprogramtranslationalmedicine-17 |

gradprogramurbandesign-17 | 
gradprogrammetabolicbiology-17 | 
gradprogramurbandesign-17-1 |

ugprogramcomparativeliterature-17 | 
ugprogrameastasianreligionthoughtandculture-17 | 
ugprogramenvironmentalsciences-17 |

ugprogramturkish-banner-17-1 | 
ugrad-environmental-design-urbanism-developing-countries-banner_17-1 | 
ugprogrampremed-banner |

ugrad-premed | 
ugrad-prelaw | 
ugprogramprelaw-banner-17-1 |

ugprogramprelaw-banner-17-2 | 
ugrad-tibetan | 
graddeptafricanamericanstudies-banner-17 |

ugdeptafricanamericanstudies-banner-17 | 
graddeptafricanamericanstudies-banner-17-1 | 
ugdeptafricanamericanstudies-banner-17-1 |

ugdeptphilosophy-banner-1-17 | 
graddeptphilosophy-banner-17-1 | 
graddeptscandinavianlanguagesliteratures-banner-17-1 |
graddeptmicrobiology-banner-17-1 | 
graddeptsciencetechnologystudies-banner-17-1 | 
ugdeptpoliticaleconomy-banner-17-1 |

ugdeptplantandmicrobialbiology-banner-17-1 | 
ugdeptpeaceandconflictstudies-banner-17-1 | 
ugdeptmiddleeasternstudies-banner-17-1 |

ugdeptmedievalstudies-banner-17-1 | 
ugdeptmediastudies-banner-17-1 | 
ugdeptglobalpovertyandpractice-banner-17-1 |

ugdeptjewishstudiescenterfor-banner-17-1 | 
ugdeptphysics-banner-17-1 | 
ugdeptstatistics-banner-17-1 |

ugdeptengineeringscience-banner-17-1 | 
ugdeptearthandplanetaryscience-banner-17-1 | 
ugdeptdevelopmentstudies-banner-17-1 |

gradprogrampublicaffairs-banner-17-1 | 
grad-public-affairs-popup-17-1 | 
grad-public-affairs-17-1 |

ugdeptamericanstudies-banner-17-1 | 
ugdeptarchitecture-banner-17-1 | 
ugdeptarthistory-banner-17-1 |

ugdeptartpracticeof-banner-17-1 | 
ugdeptastronomy-banner-17-1 | 
ugdeptbiologygeneral-banner-17-1 |

ugdeptcognitivescience-banner-17-1 | 
ugdeptcivilandenvironmentalengineering-banner-17-1 | 
ugdeptethnicstudies-banner-17-1 |

ugdeptcomparativeliterature-banner-17-1 | 
ugdeptdemography-banner-17-1 | 
ugdeptenglish-banner-17-1 |

ugdeptgeography-banner-17-1 | 
ugdeptgerman-banner-17-1 | 
ugdepthistory-banner-17-1 |

ugdeptindustrialengineeringandoperationsresearch-banner-17-1 | 
ugdeptintegrativebiologyjpg-17-1 | 
ugdeptinterdisciplinarystudies-banner-17-1 |

ugdeptitalianstudies-banner-17-1 | 
ugdeptlandscapearchitecture-banner-17-1 | 
ugdeptlatinamericanstudies-banner-17-1 |

ugdeptlinguistics-banner-17-1 | 
ugdeptmechanicalengineering-banner-17-1 | 
ugdeptmolecularandcellbiology-banner-17-1 |

ugdeptmolecularandcellbiology-banner-17-2 | 
ugdeptnuclearengineering-banner-17-1 | 
ugdeptnutritionalsciencesandtoxicology-banner-17-1 |

ugdeptphysicaleducation-banner-1-17 | 
ugdeptreligiousstudies-banner-17-1 | 
ugdeptrhetoric-banner-17-1 |

ugdeptspanishandportuguese-banner-17-1 | 
ugdepttheaterdanceandperformancestudies-banner-17-1 | 
languages-banner-17-1 |

ugdeptbuddhiststudies-banner-17-1 | 
graddeptanthropology-banner-17-1 | 
graddeptarchitecture-banner-17-1 |

graddeptarthistoryof-banner-17-1 | 
graddeptastronomy-banner-17-1 | 
graddeptbuddhiststudies-banner-17-1 |

graddeptchemicalandbiomoleularengineering-banner-17-1 | 
graddeptcityandregionalplanning-banner-17-1 | 
graddeptcivilenvironmentalengineering-banner-17-1 |

graddeptcommunicationcomputationstatistics-banner-17-1 | 
graddeptcomputationalbiology-banner-17-1 | 
graddeptcomputationalscienceengineering-17-1 |

graddeptdemography-banner-17-1 | 
graddeptenergysciencetechnology-banner-17-1 | 
graddeptethnicstudies-banner-17-1 |

graddeptfolklore-banner-17-1 | 
graddepthaasschoolofbusiness-banner-17-1 | 
graddeptindustrialengineeringoperationsresearch-banner-17-1 |

graddeptitalianstudies-banner-17-1 | 
graddeptjurisprudencesocialpolicy-banner-17-1 | 
graddeptlandscapearchitectureenvironmentalplanning-banner-17-1 |

graddeptlatinamericanstudies-banner-17-1 | 
graddeptlinguistics-banner-17-1 | 
graddeptmathematics-banner-17-1 |

graddeptmechanicalengineering-banner-17-1 | 
graddeptmedicalanthropology-banner-17-1 | 
graddeptmedievalstudies-banner-17-1 |

graddeptnanoscalescienceengineering-banner-17-1 | 
graddeptneareasternstudies-banner-17-1 | 
graddeptnewmedia-banner-17-1 |

graddeptnuclearengineering-banner-17-1 | 
graddeptperformancestudies-banner-17-1 | 
graddeptrangemanagement-banner-17-1 |

graddeptrhetoric-banner-17-1 | 
graddeptschoolofoptometry-banner-17-1 | 
graddeptsociology-banner-17-1 |

graddeptsociologyanddemography-banner-17-1 | 
ugprogramchicanolatinostudiesbanner-17-1_Yreina_Cervantez | 
ugrad-chicano-latino-studies-popup-17-1-Yreina_Cervantez |

ugrad-chicano-latino-studies-17-1 | 
grad-art-practice-popup-17-1 | 
grad-french-popup-17-1 |

grad-philosophy-popup-17-1 | 
grad-psychology-popup-17-1 | 
ugprogramarthistory-17-1 |

ugprogramdemography-banner-17-1 | 
ugrad-art-history-popup-17-1 | 
ugrad-chinese-language-popup-17-1 |

ugrad-economics-popup-17-1 | 
ugrad-film-popup-17-1 | 
ugrad-french-popup-17-1 |

ugrad-geography-popup-17-1 | 
ugrad-italian-studies-popup-17-1 | 
ugrad-philosophy-17-1 |

ugrad-public-policy-popup-17-1 | 
ugrad-society-environment-popup-17-1 | 
ugrad-statistics-popup-17-1 |

ugrad-environmental-sciences-popup-17-2 | 
ugrad-society-environment-17-2 | 
banner |

popup | 
thumbnail | 
ugprogramglobalstudies-banner-17-1 |

ugrad-global-studies-17-1 | 
ugrad-global-studies-popup-17-1 | 
grad-slavic-languages-literatures-17-1 |

grad-slavic-languages-literatures-popup-17-1 | 
gradprogramslaviclanguagesliteratures-banner-17-1 | 
graddeptfrench-banner-17-1 |

deptclassics-banner-17-1 | 
deptrhetoric-banner-17-1 | 
deptfilmandmedia-banner-17-1 |

deptcivilenvironmentalengineering-banner-17-1 | 
depteconomics-banner-17-1 | 
deptelectricalengineeringandcomputersciences-banner-17-1 |

deptcityandregionalplanning-banner-17-1 | 
deptgeography-banner-17-1 | 
deptarchitecture-banner-17-1 |

deptinternationalareastudies-banner-17-1 | 
deptearthplanetaryscience-banner-17-1 | 
deptnuclearengineering-banner-17-1 |

deptmathematics-banner-17-1 | 
deptintegrativebiology-banner-17-1 | 
deptmolecularcellbiology-banner-17-1 |

deptmolecularcellbiology-banner-17-2 | 
deptmolecularcellbiology-banner-17-3 | 
deptmolecularcellbiology-banner-17-4 |

deptgerman-banner-17-1 | 
deptenergyresources-banner-17-1 | 
deptindustrialengineeringandoperationsresearch-banner-17-1 |

deptpsychology-banner-17-1 | 
deptphilosophy-banner-17-1 | 
deptspanishandportuguese-banner-17-1 |

deptphysics-banner | 
deptlinguistics-banner-17-1 | 
deptfrench-banner-17-1 |

deptpoliticalscience-banner-17-1 | 
deptbuddhiststudies-banner-17-1 | 
depteastasianlanguagesandcultures-banner-17-1 |

deptdemography-banner-17-1 | 
deptmaterialsscienceandengineering-banner-17-1 | 
deptcomparativeliterature-banner-17-1 |

deptmedievalstudies-banner-17-1 | 
deptchemistry-banner-17-1 | 
deptsouthandsoutheastasianstudies-banner-17-1 |

ugrad-logic-17-1 | 
ugrad-logic-popup-17-1 | 
ugradprogramlogic-banner-17-1 |